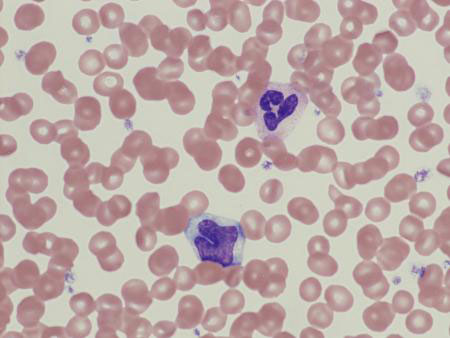
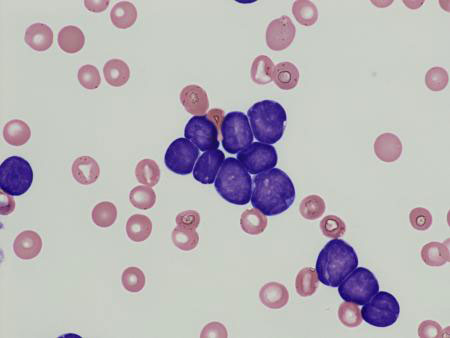
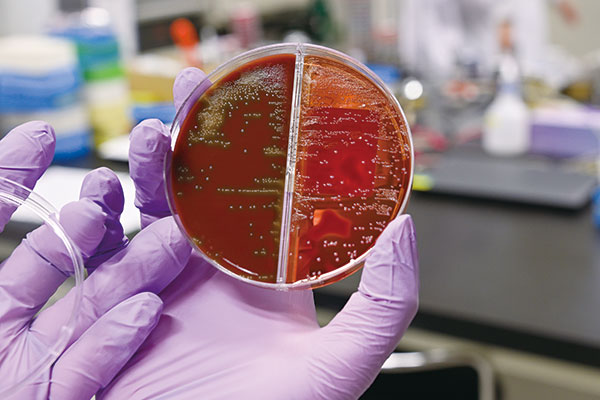

株式会社アイルは、130を超える病院・医療施設を擁するIMSグループ傘下の臨床検査センターです。
設立42周年を迎え、臨床検査の専門的知識と高精度な検査結果の提供により、患者さま・入所者さまの日々の健康維持、向上をサポートすることを基本理念としています。
臨床検査は疾病の早期発見や予防、治療の判断に欠かせません。検査分野は生化学・免疫学・血液学・微生物学・病理学。より高度な専門技術を備えたアイルと、各病院内の臨床検査部門とが、共通の検査システムを導入し、迅速、正確、高精度な検査データの報告に努めています。
2018年3月には臨床検査のトップランナーとして、「ISO 15189(臨床検査室―品質と能力に対する要求事項)」の認定を取得。これは検査室の品質マネジメントシステムと臨床検査の技術能力を求める国際規格であり、ISO(国際標準化機構)により設定されたもの。さらに本年8月には派遣された審査員による審査を経て最新の2022年度版に更新しました。
血液成分の分析装置

白血球・赤血球・血小板の個数、分布、形状などを測定。1時間に約400件を処理する
顕微鏡でチェック

光学的顕微鏡で標本を確認

ISO 15189の認定証
血液学的検査
健常な血液の顕微鏡写真
様々な種類の白血球がバランスよく分布
白血病が疑われる血液
異常細胞が大半を占めている(普通の白血球が認められない)